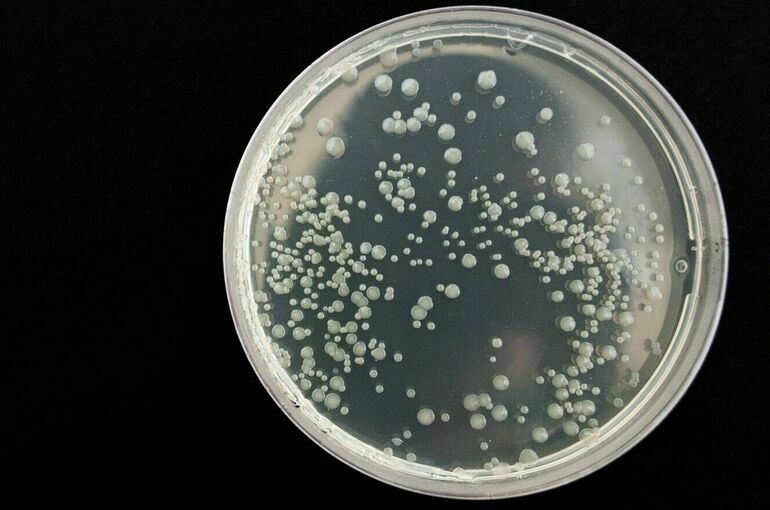

Кабмин утвердил правила создания и ведения каталога вирусов
Правительство утвердило правила, которые будут регулировать финансовое и материально-техническое обеспечение создания, пополнения и ведения каталога микроорганизмов и вирусов. Соответствующее постановление подписал председатель Правительства Михаил Мишустин.
Собрать все известные патогены в одной коллекции решили во исполнение Закона «О биологической безопасности». Определять, какие именно бактерии, грибы и вирусы вносить в список и кто сможет это делать, будет кабмин.
Каталог станет единой национальной базой, в которую будет собрана вся информация из отечественных и международных источников о вызывающих болезни микроорганизмах. Планируется, что база будет регулярно пополняться.
Созданием и ведением национального каталога патогенов будет заниматься Государственный научный центр прикладной микробиологии и биотехнологии, подведомственный Роспотребнадзору.
«Учёные смогут использовать коллекции в своих исследованиях, среди прочего при разработке вакцин», — сказал Мишустин.
Согласно утверждённым правилам, материально-техническое обеспечение коллекции патогенов должно включать лабораторное оборудование, расходные материалы и реактивы, обеспечение биологической безопасности и физической защиты коллекций патогенов, информационно-техническое обеспечение коллекционной деятельности и поддержание инфраструктуры помещений, в которых ведётся работа с патогенами.
Кроме того, правила устанавливают, что финансовое обеспечение коллекционирования патогенов будет происходить за счёт федерального бюджета, а финансирование бюджетных и автономных учреждений осуществляется за счёт субсидий.
Также правила устанавливают, что финансирование предусматривает расходы на зарплату сотрудникам, закупку оборудования и расходных материалов, а также приобретение штаммов патогенов, клеточных культур, бактериофагов, генетических конструкций и другие расходы.
Кроме того, учреждения, в которых создаются коллекции патогенов, должны формировать ежегодный план своей деятельности. В том числе план должен содержать планируемое количество включения новых штаммов патогенов.
Ранее член Комитета Совета Федерации по социальной политике Владимир Круглый рассказал «Парламентской газете» о том, что база патогенных микроорганизмов абсолютно необходима и из-за многочисленных вопросов о COVID-19: откуда он взялся, рукотворный он, или это утечка материалов, или это какие-то новые мутации?
Глава Роспотребнадзора Анна Попова сообщила о том, что для оперативного выявления возбудителей инфекций будет развиваться национальная лабораторная инфраструктура. Новые лаборатории должны позволить расшифровывать любую неизвестную инфекцию за 24 часа, начинать исследования для скорейшей разработки средств диагностики и профилактики.




 2300
2300






